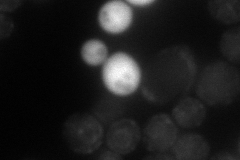
YDL070W
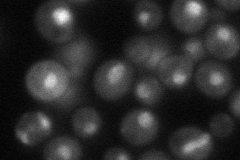
YDL070W

View description
Protein involved in transcription initiation at TATA-containing promoters; associates with the basal transcription factor TFIID; contains two bromodomains; corresponds to the C-terminal region of mammalian TAF1; redundant with Bdf1p
Localization:
Intensity:
Fold change:
Significance:
-
C’ GFP library in SD

nucleus46.28 -
N' NOP1pr-GFP in SD
cell periphery,ER,punctate45.4143 -
N' TEF2pr-mCherry in SD

cell periphery,vacuole19.7099 -
N' NATIVEpr-GFP in SD
nuclear periphery49.3582 -
N' TEF2pr-VC and Cyto-VN in SD

#N/A0 -
C’ GFP library in SD+DTT

nucleus31.880.68No -
C’ GFP library in SD+H2O2

nucleus54.761.18No -
C’ GFP library in Starvation Media

nucleus29.10.62Yes -
C’ GFP library on the background of Pup2-DaMP

nucleus -
C’ GFP library on the background of CCT mutant

nucleus46.91991.01371No
